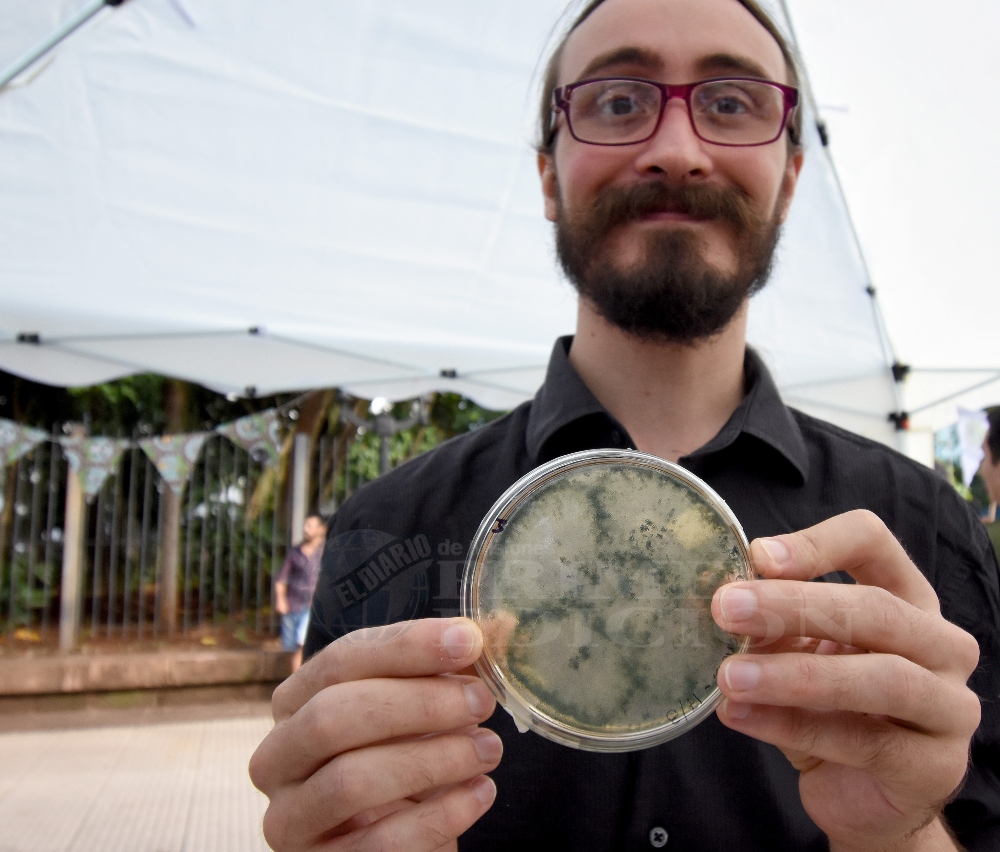

Equipos e investigadores de la Facultad de Ciencias Exactas, Químicas y Naturales de la Universidad Nacional de Misiones (UNaM) se encontraron ayer con curiosos y estudiantes de todos los niveles para poner la ciencia en movimiento en medio de la plaza 9 de Julio de Posadas.
Durante toda la mañana, hubo stands interactivos colmados de interés por la ciencia, donde el complejo contexto que atraviesan la producción científica y las universidades nacionales argentinas no pasó desapercibido.
Es que la falta de presupuesto apareció en cada uno de los testimonios que recogió PRIMERA EDICIÓN en el evento, siguiendo el recorrido desde los estudiantes y tesistas que trabajan con insumos vencidos o reciclados, hasta docentes e investigadores que ven el impacto del recorte en su salario y en becas sin otorgar.
Hacer ciencia en medio del ajuste
Abril Molinari fue una de las estudiantes que se animó a participar en esta experiencia compartida entre la facultad y la comunidad. Cursando el tercer año de la Licenciatura en Análisis Químicos y Bromatológicos, formó parte de “El rincón de laboratorio”.
En el stand, que estaba colmado de chicos desde el inicio de la mañana, mostraron cultivos de bacterias y hongos a través de un microscopio, además de una escala de pH en colores y burbujas de glicerina, para que los asistentes “conozcan un poquito de todo lo que se hace en el laboratorio y de lo que se puede hacer en casa también”, resumió.
La emoción de los chicos cada vez que se acercaban al microscopio contrastaba con el panorama que describió Abril. “Estamos pasando por un momento complicado en la facultad, en la universidad pública”, aseguró, en referencia a los problemas presupuestarios y cómo se reflejan en el día a día.
Ver esta publicación en Instagram
“Los reactivos que ocupamos todos los días en el laboratorio están vencidos, o escasos, o no se consiguen. A veces nos pasa incluso que hay microscopios que no sirven y no se pueden cambiar”, contó.
Esa falta de insumos impacta en cómo cursan. “En un laboratorio a veces somos 15, como podemos ser 30. Y el laboratorio es un espacio reducido. La mayoría de las veces tenemos que trabajar en grupos de a cinco, de a 10, para ver en un microscopio y de los 10 que precisamos andan ocho”, relató.
En el caso de los estudiantes avanzados, el problema se agrava. Uno de ellos es Mikel Goicochea, tesista de la Licenciatura en Genética que también acompañó la kermés y expuso sus avances en la identificación y uso de hongos nativos para el control biológico de plagas.
Cada hongo incluido en el proyecto que integra es el resultado de hasta diez años de trabajo compartido entre varios investigadores y Goicochea contó que hoy deben recurrir a alternativas para cubrir lo que falta.
El reciclado es una de las estrategias que pisa fuerte. “Este es un frasco de café que literalmente lo traje de mi casa. Algunas de estas placas son placas de plástico que estamos reciclando. Normalmente no se hace eso. Estamos en una condición de que no podemos gastar ni para las placas”, ejemplificó. También afecta los avances de la investigación: en el cultivo de los hongos, contó que hoy utiliza recursos menos efectivos, como el arroz, para reducir costos.
Orgullo y compromiso
Más allá del escenario adverso, Goicochea destacó que el trabajo del investigador “es muy gratificante” y se refirió al compromiso personal que hay detrás de cada trabajo.
“Es frustrante a veces también, porque es dedicarle meses y años de tu tiempo y tardás en ver los resultados. Pero realmente es muy gratificante saber que lo que estás haciendo realmente puede marcar la diferencia”, completó.
Paula Fernández, doctora en Ciencias Aplicadas e ingeniera química egresada de la FCEQyN, también aportó su punto de vista. Formada desde su título de grado en la UNaM, donde también alcanzó su doctorado, aseguró que hoy ese camino recorrido es sinónimo de “orgullo”.
“La universidad me formó. Me dio trabajo porque soy docente también de la universidad. Hacemos todo, investigación y extensión, y da a conocer a la comunidad que existen estas muchísimas carreras”, aseguró la investigadora.
Sobre la situación actual de la ciencia y la universidad, completó la postal del ajuste con la desactualización salarial y los recortes en becas, ya que fue seleccionada en la convocatoria 2022 para ser investigadora del CONICET y aún no le dieron el alta.
“El docente universitario hoy cobra menos que docentes de secundario y terciario. Estamos siendo formadores de formadores y el sueldo no es justo”, sostuvo Fernández.